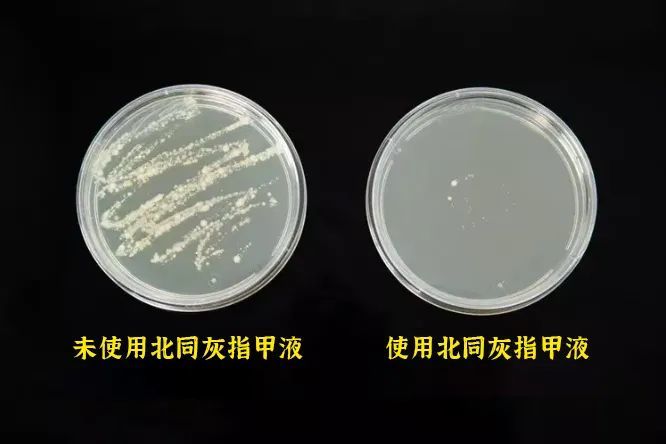

春夏一到,气温升高,雨水增多,特别是南方,很多朋友已经开始被潮湿天气困扰了。
然鹅,最难受的还不只是天气,而是潮湿+升温带来的问题——
有研究调查发现,湿热环境下有细菌感染不适症状的患者高达93.6%。
除了常见的湿疹等皮肤问题的,还有种危害你最容易忽视——灰指甲!

指甲发黄发黑、粗糙变厚,还有淤血,藏在鞋子里的尴尬,根本不敢脱鞋见人!

气温一升高,灰指甲的犯病率就会迅速提升。
真菌乘虚而入,感染的风险极速飙升!!
你一定听过,灰指甲一个传染俩!
传染自己!真菌蔓延至周边皮肤部位导致手癣、脚气!

传染家人!不管是直接接触,还是间接接触,灰指甲都容易传染。
小孩的免疫力弱、抵抗力差,更容易被传染,要是因为这个在学校里被歧视,那真是一辈子的阴影!

老年人得灰指甲更是常见,脏丑另说,抱孙子孙女怕传染,更怕被她们嫌弃伤心!

因为灰指甲不痛、不痒,很多人一开始并不在意,事实上治疗灰指甲一定要趁早。
如果不引起重视,很可能引起并发问题(甲沟炎、甲床炎),到时候后悔都来不及。

一分钟判断有无灰指甲
①指甲浑浊、不透明
②指甲增厚,比正常甲板厚 1 ~ 3 倍以上
③指甲表面粗糙、凹凸不平、失去光泽
④指甲板变脆易碎,脱落碎杂
⑤指甲表层与指肉分离,中空现象
如果有1~2个症状,就说明你可能中招了!

得了灰指甲到底怎么治?
需不需要拔甲?口服药是不是副作用很大?
很多人相信路上的小广告,洗脚店的项目,交了不少智商税,花了不少冤枉钱!灰指甲挥之不去!
小编也深受其害,拔甲(很受罪)、服药(副作用很大)都试过,总结下来外用药才是最合适的。

因为我的灰指甲就是涂外用搞好的。
原本我的指甲增厚、发黄、掉渣还空甲。
早晚各涂一次,坚持了有快一个月那些坏甲就无痛脱落了。

后期因为工作忙,有时候忘了涂,一直到快三个半月指甲才完全恢复健康。
虽然有点慢,但是效果确实肉眼可见。停用后一直也没见复发,我才彻底安心了。
如果你和小编一样得了灰指甲,推荐大家用这款!
北京同仁堂灰指甲抑菌液
中草配方+抑菌修护
早晚一滴,坏甲换新甲
速吸速干,不脏手不脏脚
从此告别灰甲,恢复亮甲!

这款真的是小编淘汰了几十款灰指甲液选中的!
之前用的*甲抑菌效果根本不行,一盒八十多,大几百结果指甲长出来还是灰指甲。

因为是纯草配方,对皮肤没有刺激,12味草本添加量精确到0.1%,使用起来非常安心。
只要在指甲上滴一滴,软化角质、舒缓灭炎、滋养甲床,一个月老指甲脱落,三个月长出圆润光泽的健康新甲。

抑菌效果经过专业机构检测,质量杠杠的!

因为安全性高,效果出众,北京同仁堂灰指甲液一上市就受到各大药房推荐,消费者青睐。
据统计,目前已经帮助数万人解决脚部问题。


推荐理由

• 北京同仁堂,百年老字号出品,品质效果有保障;
• 早晚一滴,2分钟吸收,快速制服真菌,灰甲褪去,新甲重生;
• 多种草本精粹,添加医用级成分,精准配比,温和安全,不刺激皮肤。
点击下方,立即购买👇

北京同仁堂百年品牌
去灰甲更靠谱
说起北京同仁堂这个品牌,相信大家都很熟悉~
始于1688年,康熙曾写下“同修仁德,济世养生”,便有了同仁堂,一直延续至今。

现在已经发展成集现代制药,零售商业,医疗服务于一体的制药集团,业务和品牌门店遍布15个国家和地区,在社会具有较高认可度、知名度、美誉度。

同仁堂中医药文化甚至进入国家非物质文化遗产名录,这是几百年的积淀才有的殊荣。


70天灰指甲脱落
长出健康新甲
为什么在这个时间点推荐这款灰指甲液?
说实话最近向小编求助的粉丝非常多,让我想起了自己的惨痛经历。
为什么大家治了这么久的灰指甲,还是无果?因为你太想治好灰指甲了!

可你知道吗?人的指甲平均的长度为16mm,生长速度是每天0.1㎜,完全长新甲大约是5个月左右!
那些招摇撞骗的灰指甲产品,“7天、14天就能长出新指甲!”,真是吹牛不打草稿。
小编可不敢夸这海口,因为北京同仁堂灰指甲液也是办不到的。
但是经过无数次优化改良,既保障效果,也将时间尽可能缩短。注:程度不同会有差别。



去灰甲,三步走
釜底抽薪更有效
很多人不知道为什么会得灰指甲,其实本质是因为指甲/趾甲的真菌感染。
而灰指甲之所以麻烦难治,原因就在于真菌没有断根,反复出现。
所以对付灰指甲的第一步就是:灭菌、抑菌!

这款灰指甲液添加了12种植物草本,经过黄金配比,具有非常好的抑菌作用。

经过超微分子处理,灰指甲液渗入性高。可以从指缝处渗入甲板-甲床,直至甲根杀灭真菌。

不仅如此,灰甲液还加入了医用级的广谱抑菌剂——醋酸氯已定!
这可是医生手术前消毒用的成分,还经常用于皮肤创面的效果,效果好又安心!
注:醋酸氯已定含量为0.1%~0.3%在安全标准内,对人体完全无害。

效果有多强?小编给大家做了一组实验!
找来了有脚气的同事的鞋子,采集了一些真菌样本进行培养。
用灰指甲液进行对照。

结果,一边是细菌痕迹明显,而灰指甲液所在的培养皿几乎没有菌落!
实验过程将近24小时,说明灰指甲液是可以长时间保护指甲的。
这就是对付灰指甲的第二步:形成生物膜。24小时不间断地避免菌落入侵,断了灰指甲反复的可能。

这样就完了吗?第三步才是快速养出漂亮美甲的关键!
否则,手上的灰指甲需要5个月以上,才能恢复,脚趾甲甚至超过9个月。
人的指甲成分,主要是由角质蛋白,而北京同仁堂研发团队在配方里加入了修护养甲的草本精粹,能让指甲生长的更快。

一方面可以提供甲床细胞恢复的营养所需,增强自身的防护力。
另一方面,这些精华好比“指甲催生剂”,对角质蛋白的合成有加快作用,涂上去,指甲就像雨后春笋一样突突地冒出头,长出健康圆润饱满的亮甲。

来看看其他用户真实的使用效果。

这些走心的反馈和评价,只有真正使用过才能感受到的!希望这么有效的灰指甲液,能帮助更多的患者恢复亮甲!



坚持使用,温和养护
灰指甲一去不复返!
得了灰指甲,皮肤患处相对健康肌肤会很脆弱,尤其是甲床。
所以坚决抵制大量化学添加的灰指甲液!
而北京同仁堂灰指甲液,配方全是植物提取物,不含挥发药理学、免疫学及代谢的成分。

而且各种成分的用量,都是经过科学实验配比出来的,对皮肤没有刺激性,不伤肤。

小编还进行了PH测试,数值为5-6弱酸性,接近人体的酸碱环境,直接涂在指甲缝里也很安心。

用起来就跟涂指甲油一样,基本上2分钟就干透了。
真正做到不包扎,不修甲,不痛地修复灰甲。

再也不怕和客户握手,夏天能尽情地穿拖鞋、凉鞋。

和家人朋友接触也不怕有传染风险,整个人都自信开朗了。

但是切记大家要坚持使用!
千万不要急功近利,因为灰甲比一般的皮肤问题都难恢复,更容易反复发作,坚持很重要。

北京同仁堂官方售价59元/瓶。
我们平台发售,单瓶售价49元,直降10元!第二瓶半价只要73.5元!
一瓶大概能用1个月左右,根据小编恢复的时间来算,建议大家选择买3送1,再减10元的规格。4瓶刚刚好够一个疗程。算下来一瓶只要34元!!
如果灰指甲比较严重,建议大家下单两个疗程,毕竟灰指甲不是一朝一夕的事情!
相信我,你的灰指甲这次会好的!

每瓶包装上有防伪码可查,大家可以放心下单。

扫码关注“小来生活馆”公众号
即可领取5元无门槛优惠券!
除此之外,还有超值好礼!
关注公众号即可参与幸运大抽奖
最高可以获得价值3000元戴森吸尘器!
▼点击下方关注


